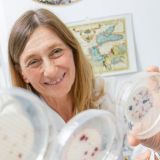
Regina Sommer

Center for Pathophysiology, Infectiology and Immunology (Institute for Hygiene and Applied Immunology)
Position: Associate Professor
ORCID: 0000-0002-7781-1915
T +43 1 40160 33051
regina.sommer@meduniwien.ac.at
Keywords
Bathing Beaches; Disinfection; Drinking Water; Hemodialysis Solutions; Hygiene; Swimming Pools; Ultraviolet Rays; Water Microbiology; Water Pollutants, Chemical; Water Quality; Water Supply
Research group(s)
- Water Hygiene
Head: Regina Sommer
Research Area: Our research area deals with all aspects of ,
Members:
Research interests
The main focus of our research is water quality and health. Our aim is to understand and prevent infections via the water route and to avoid intoxications due to contaminated water. A special fous is laid on the challenges regarding water quality in health care facilities. Engineered water systems like cold and hot water supplies, therapy pools, cooling towers and devices for the production of hemodialysis fluids have been recognized as important sources for nosocomial infections, e.g. by legionellae and other water bacteria. Water disinfection is one of the most powerful tools to inactivate pathogenic microorganisms. We could prove that UV irradiation is a valuable water disinfection method. Our research led to an reliable application and a national and international standardisation of UV technology.
Our Water Hygiene unit is partner of the Interuniversity Cooperation Center Water & Health, a cooperation established between the Vienna University of Technology (TU) and the Medical University of Vienna (MedUni). Our Center focuses on research and teaching at the international level and scientific leadership in the areas of water and health as a competent partner for both the public sector and business (www.waterandhealth.at).
Techniques, methods & infrastructure
We have established an Accredited testing laboratory and inspection body, which include a wide range of microbiological, physical and chemical methods for water analysis as well as for on-site inspections.
Examples for special parameters are heavy metals, total organic carbon, halogenated carbons, bacterial endotoxines and cultivation techniques for bacteria and bacteriophages.
For the investigation of the UV resistance of microorganisms we have developed a standardized UV inactivation apparatus as well as a device for the photoreactivation of bacteria.
We have built up the Water Test Centre Wiental for full-size testing of UV systems for water disinfection, which enables us to transfer our laboratory research into application (www.uv-team-austria.at).
Grants
- triboREMEDY (2019)
Source of Funding: EU, H2020-FETOPEN-2018-2020/H2020
Principal Investigator
Selected publications
- Cervero-Arago, S., Sommer, R. & Araujo, R.M., 2014. Effect of UV irradiation (253.7 nm) on free Legionella and Legionella associated with its amoebae hosts. Water Research, 67, pp.299-309. Available at: http://dx.doi.org/10.1016/j.watres.2014.09.023.
- Derx, J. et al., 2016. QMRAcatch: Human-Associated Fecal Pollution and Infection Risk Modeling for a River/Floodplain Environment. Journal of Environment Quality, 45(4), p.1205. Available at: http://dx.doi.org/10.2134/jeq2015.11.0560.
- Guerrero-Latorre, L. et al., 2016. UV disinfection and flocculation-chlorination sachets to reduce hepatitis E virus in drinking water. International Journal of Hygiene and Environmental Health, 219(4-5), pp.405-411. Available at: http://dx.doi.org/10.1016/j.ijheh.2016.04.002.
- Martzy, R. et al., 2017. A loop-mediated isothermal amplification (LAMP) assay for the rapid detection of Enterococcus spp. in water. Water Research, 122, pp.62-69. Available at: http://dx.doi.org/10.1016/j.watres.2017.05.023.
- Sommer, R., Lhotsky, M., Haider, T., & Cabaj, A. (2000). UV inactivation, liquid-holding recovery, and photoreactivation of escherichia Eoli O157 and other pathogenic Escherichia coli strains in water. Journal of Food Protection, 63(8), 1015-1020. Retrieved from www.scopus.com